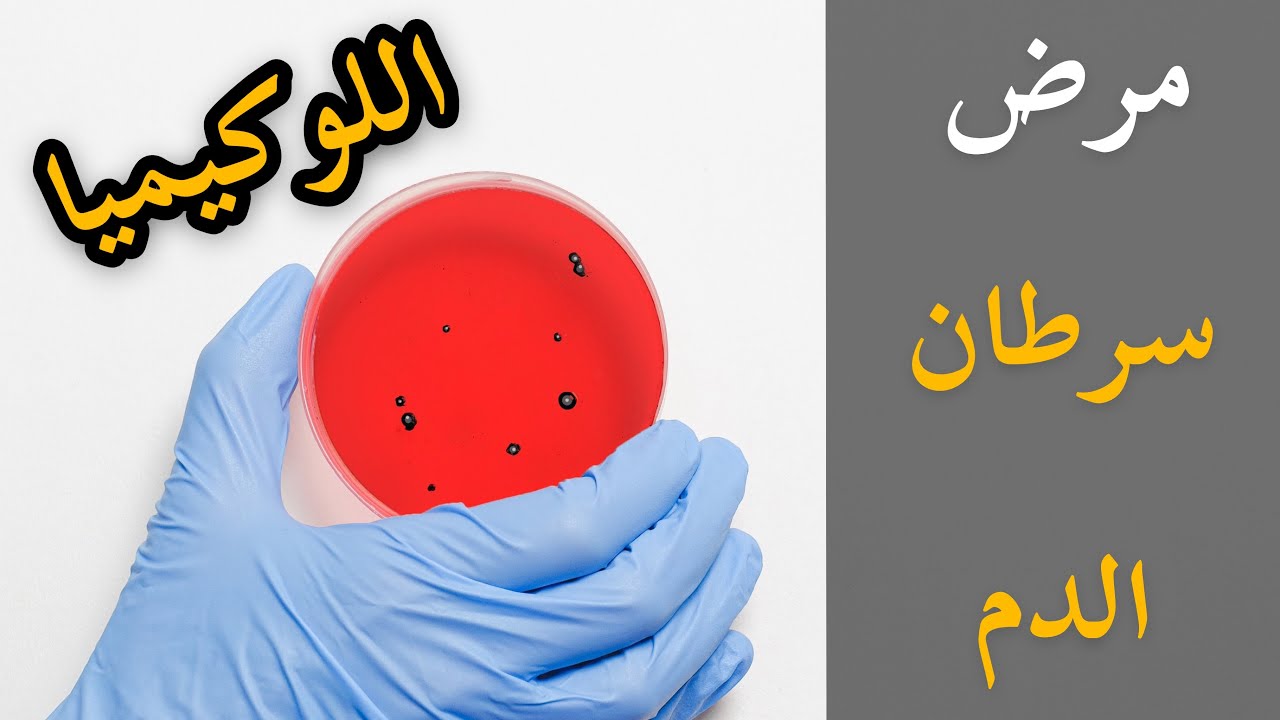

عاجل| تحت اسم ”أوتزيفرا” روسيا تعلن عن إنتاج أول دواء محلي لعلاج سرطان الدم بالمجان

أعلنت روسيا انتهائها من التجارب السرية لابتكار دواء محلي لعلاج سرطان الدم تحت اسم "أوتزيفرا" (Utzhefra) ومن المتوقع تسجيله هذا العام 2026
تصريحات الانتهاء من علاج سرطان الدم في روسيا
صرحت المديرة العامة للمركز الوطني للبحوث الطبية الروسية في مجال أمراض الدم إيلينا باروفيتشنيكوفا عن استكمال الباحثين لأول تجربة سريرية في البلاد لاستخدام خلايا CAR-T لعلاج المرضى المصابين بابيضاض الدم الليمفاوي الحاد، والأورام اللمفاوية من الخلايا البائية الإيجابية لـ CD19.
سيتاح "أوتزيفرا" بالمجان لعلاج الأمراض الخبيثة في الدم
كما أوضحت باروفيتشنيكوفا إدراج بند يلتزم بإجبارية تمويل جميع حالات استخدام علاج خلايا CAR-T للمرضى لإتاحة العلاج مجانًا.
أعلن ميخائيل ميشوستين رئيس الوزراء الروسي عن توسع برنامج الضمانات الحكومية لإتاحة حصول المريض علي جميع العلاجات من ضمنها علاجات السرطان والعلاج بتقنية CAR-T ضمن نظام التأمين الصحي الإلزامي لكل مواطن.
























